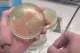
Xác Định Độ Nhạy Kháng Sinh trong Nuôi Tôm Thẻ Chân Trắng

Mối Quan Hệ Chiến Lược: Entobel và Vĩnh Hoàn Đồng Hành Trong Sự Phát Triển Bền Vững của Ngành Nuôi Cá Tra
Triển vọng của protein côn trùng trong thức ăn cho cá tra ở Việt Nam đang trở nên rõ ràng hơn qua mối quan hệ mới giữa Entobel và Vĩnh Hoàn. Hai công ty này đã ký kết quan hệ đối tác chiến lược để mở rộng việc sử dụng thức ăn làm từ côn trùng trong ngành nuôi cá tra. Thỏa thuận này bao gồm việc Vĩnh Hoàn mua một lượng lớn protein côn trùng từ nhà máy của Entobel tại Vũng Tàu. Đây được xem là một bước quan trọng trong việc phát triển chuỗi cung ứng nuôi trồng thủy sản bền vững và giảm tác động môi trường. thông qua việc áp dụng protein côn trùng, ngành nuôi cá tra ở Việt Nam có thể tạo ra thức ăn có lợi ích dinh dưỡng và miễn dịch, đồng thời giảm tác động tiêu cực lên môi trường.
Việc mở rộng quy mô nhà máy sản xuất protein côn trùng tại Vũng Tàu của Entobel vào năm 2023 cũng đã tạo ra cơ sở vững chắc cho quan hệ hợp tác này. Điều này thể hiện niềm tin vào khả năng của Entobel trong sản xuất protein côn trùng trên quy mô lớn và với mức chi phí cạnh tranh. Mối quan hệ hợp tác này không chỉ mở ra cơ hội kinh doanh mà còn giúp nâng cao năng lực sản xuất và cung cấp protein côn trùng của Entobel cho thị trường toàn cầu.
Entobel đang tiến đến vòng cấp vốn Series C vào quý 2 năm 2024 để hỗ trợ kế hoạch tăng trưởng khu vực của mình. Công ty này cũng đang chuẩn bị xây dựng cơ sở mới tại các thị trường trọng điểm như Việt Nam, Indonesia và Malaysia. Sứ mệnh của Entobel là cung cấp mảnh ghép còn thiếu trong chuỗi lương thực toàn cầu bằng cách chuyển đổi phụ phẩm giá trị thấp thành sản phẩm có ích nhờ côn trùng.
Entobel không chỉ tập trung vào khía cạnh kinh doanh mà còn chú trọng vào việc giảm thiểu rủi ro trong hoạt động và công nghệ của mô hình kinh doanh. Công ty này cũng thể hiện lực kéo thương mại mạnh mẽ cho các sản phẩm của mình. Mối quan hệ hợp tác giữa Entobel và Vĩnh Hoàn không chỉ là một cơ hội kinh doanh mà còn đóng góp vào sự phát triển bền vững của ngành nuôi cá tra ở Việt Nam và toàn cầu.